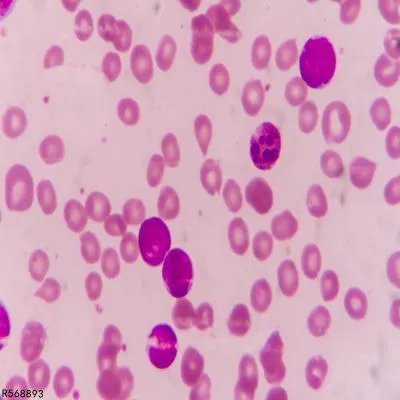
沙门菌食物中毒的常见症状和预防措施

很多人对沙门菌不是很了解,像我们日常食用的牛肉、鸡肉、牛奶、鸡蛋很容易感染上沙门菌,经过污染的食物在外形与味觉上我们肉眼是无法分辨出来,今天我们大家就来看看哪种情况是由于沙门菌食物中毒引起的呢?常见的预防又有哪些呢?
一:沙门菌食物中毒的常见症状
1、伤寒:感染初期会引发头痛,发热不适、如果没有及时的治疗后出现呕吐、腹泻、脱水严重的会引发痉挛、休克等。
2、引发肠炎:在感染后的12~24小时,如果细菌产生毒素,可引发中枢神经系统症状抽搐与昏迷。
3、引发败血症:该病症主要发生在岁数比较小的儿童,新生儿身上,虽然主要表现为腹泻,发展成为败血症,由于新生儿的体抗力比较低,易引发感染。
出现症状时要及时的治疗,这样才能在最短的时间内帮助孩子恢复。
二:保证食物健康的最有效的方法
1、加大食品卫生的检查强调,防止生前感染的动物流入市场,避免宰杀后后感染其它。
对于肉类的检疫,以及宰杀的卫生环境以及流通一定要要严格的把关。
2、注重自身卫生情况,在接触到动物的粪便后要立即洗手。
3、在食用肉类的时候要避免食用生的、半生的饮用牛奶或其制品要经过消毒的。
4、没有烹制过的肉类要和水果以及蔬菜都要分开存放,避免交叉感染。
水果蔬菜在食用时要把农药洗干净。
以上关于沙门菌食物中毒的症状和危害相信大家都了解了,我们以后都会注意自己的饮食健康,预防沙门菌食物中毒就从彻底清洗开始吧!
清洗瓜果蔬菜,勤洗手,这些小事是我们最容易做到的,快快行动起来吧,今天你的饮食健康吗?
